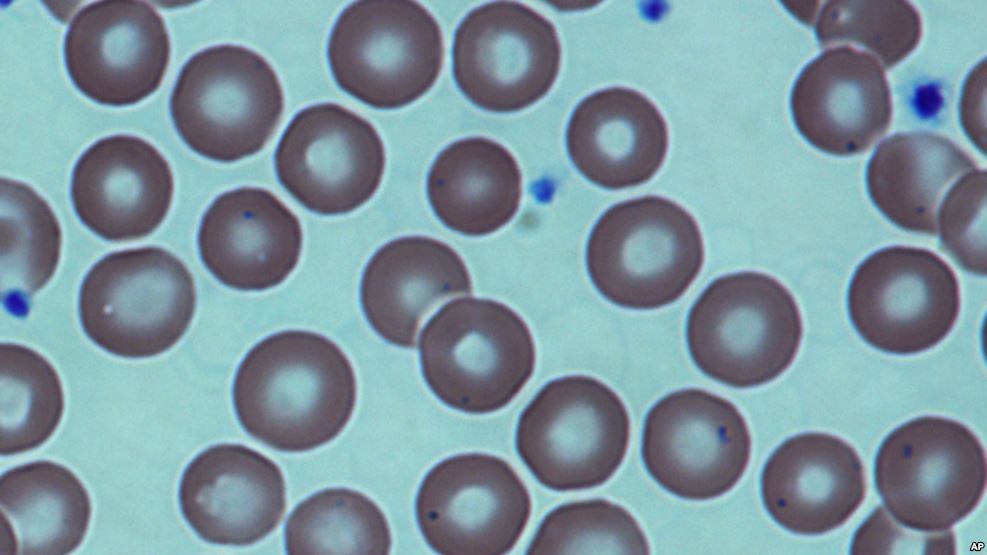
Bientôt des greffes de moelle osseuse sans chimiothérapie, moins dangereuses
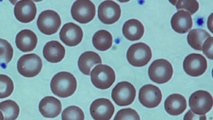
Bientôt des greffes de moelle osseuse sans chimiothérapie, moins dangereuses

Miami, Etats-Unis | AFP | mercredi 10/08/2016 - Des greffes de moelle osseuse sans chimiothérapie et donc moins dangereuses pour les patients pourraient bientôt être possibles, ont annoncé mercredi des chercheurs américains après le succès d'une l'expérience sur des souris.
La méthode développée par une équipe de scientifiques de l'université de Stanford imite l'approche utilisée dans l'immunothérapie, où les patients atteints d'un cancer suivent un traitement qui "entraîne" en quelque sorte leur système immunitaire à tuer lui-même les cellules cancéreuses.
Si la méthode fonctionne chez l'homme, elle pourrait aider à améliorer les traitements pour le lupus, le diabète juvénile, la sclérose en plaques, les greffes d'organes et même le cancer.
"Il n'y a presque pas de maladie ou de greffe d'organe qui ne soit pas concernée par cette étude", a déclaré Irving Weissman, professeur de biologie et de développement cellulaire à Stanford et co-auteur du rapport publié dans la revue Science Translational Medicine.
Pour l'instant, toute personne qui reçoit une greffe de moelle osseuse, également appelée greffe de cellules souches, est contrainte de subir une chimiothérapie ou une radiothérapie afin de détruire d'abord ses propres cellules souches.
Ce traitement souvent toxique et agressif peut rendre l'opération chirurgicale dangereuse, voire fatale dans un cas sur cinq. L'opération est également susceptible d'endommager les organes ou de créer des lésions nerveuses et cérébrales.
Pour leur expérience, les chercheurs ont mis au point une nouvelle approche comprenant un anticorps et des agents biologiques qui aident le système immunitaire des souris à réduire de lui-même les cellules souches, pour ensuite céder la place aux cellules du donneur.
"Si ça marche sur l'homme comme ça a marché sur les souris, nous espérons que le risque de décès passe de 20% à zéro", a affirmé l'auteur principal de l'étude, Judith Shizuru, professeur de médecine à Stanford.
Des études sur l'homme seront bientôt réalisées.
La méthode développée par une équipe de scientifiques de l'université de Stanford imite l'approche utilisée dans l'immunothérapie, où les patients atteints d'un cancer suivent un traitement qui "entraîne" en quelque sorte leur système immunitaire à tuer lui-même les cellules cancéreuses.
Si la méthode fonctionne chez l'homme, elle pourrait aider à améliorer les traitements pour le lupus, le diabète juvénile, la sclérose en plaques, les greffes d'organes et même le cancer.
"Il n'y a presque pas de maladie ou de greffe d'organe qui ne soit pas concernée par cette étude", a déclaré Irving Weissman, professeur de biologie et de développement cellulaire à Stanford et co-auteur du rapport publié dans la revue Science Translational Medicine.
Pour l'instant, toute personne qui reçoit une greffe de moelle osseuse, également appelée greffe de cellules souches, est contrainte de subir une chimiothérapie ou une radiothérapie afin de détruire d'abord ses propres cellules souches.
Ce traitement souvent toxique et agressif peut rendre l'opération chirurgicale dangereuse, voire fatale dans un cas sur cinq. L'opération est également susceptible d'endommager les organes ou de créer des lésions nerveuses et cérébrales.
Pour leur expérience, les chercheurs ont mis au point une nouvelle approche comprenant un anticorps et des agents biologiques qui aident le système immunitaire des souris à réduire de lui-même les cellules souches, pour ensuite céder la place aux cellules du donneur.
"Si ça marche sur l'homme comme ça a marché sur les souris, nous espérons que le risque de décès passe de 20% à zéro", a affirmé l'auteur principal de l'étude, Judith Shizuru, professeur de médecine à Stanford.
Des études sur l'homme seront bientôt réalisées.